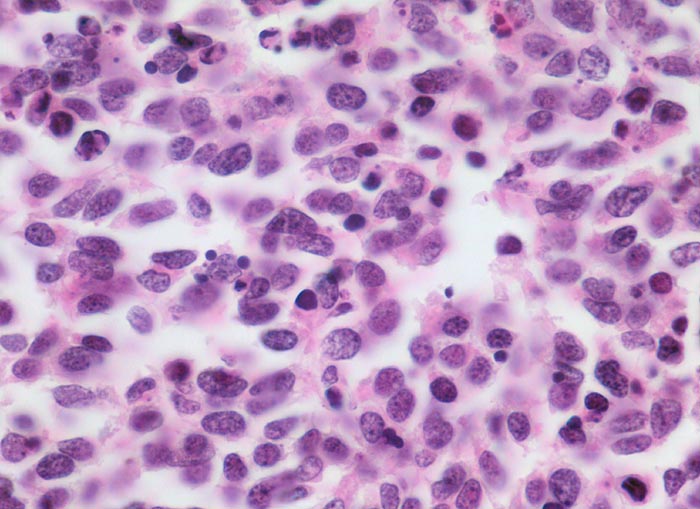

PathoPic – image database / PathoPic ID 4718 - kleinzelliges Bronchuskarzinom
de
Diagnose
kleinzelliges Bronchuskarzinom
Diagnose Gruppe
maligner Tumor
Topographie
Lunge
Topographie Gruppe
Lunge, Mediastinum mit Thymus
Beschreibung
Tumorzellen mit sehr schmalem Zytoplasmasaum und eckigen, ovalen oder rundlichen Kernen mit feinkörnigem Chromatin. Nukleolen sind nicht erkennbar oder sehr klein. Der Kern einer Plasmazelle ist etwas kleiner als die Tumorzellkerne und hat eine typische Radspeichenstruktur des Chromatins. Die Plasmazelle hat auch deutlich mehr Zytoplasma. Zahlreiche apoptotische Tumorzellen.
Klinik
Inoperables metastasierendes Bronchuskarzinom. Nikotinabusus 70 Packyears.
Bilder Typ
Histologie
Vergrösserung
630
Alter
55
Geschlecht
männlich
Datum
Ersteintrag: 06.10.2002